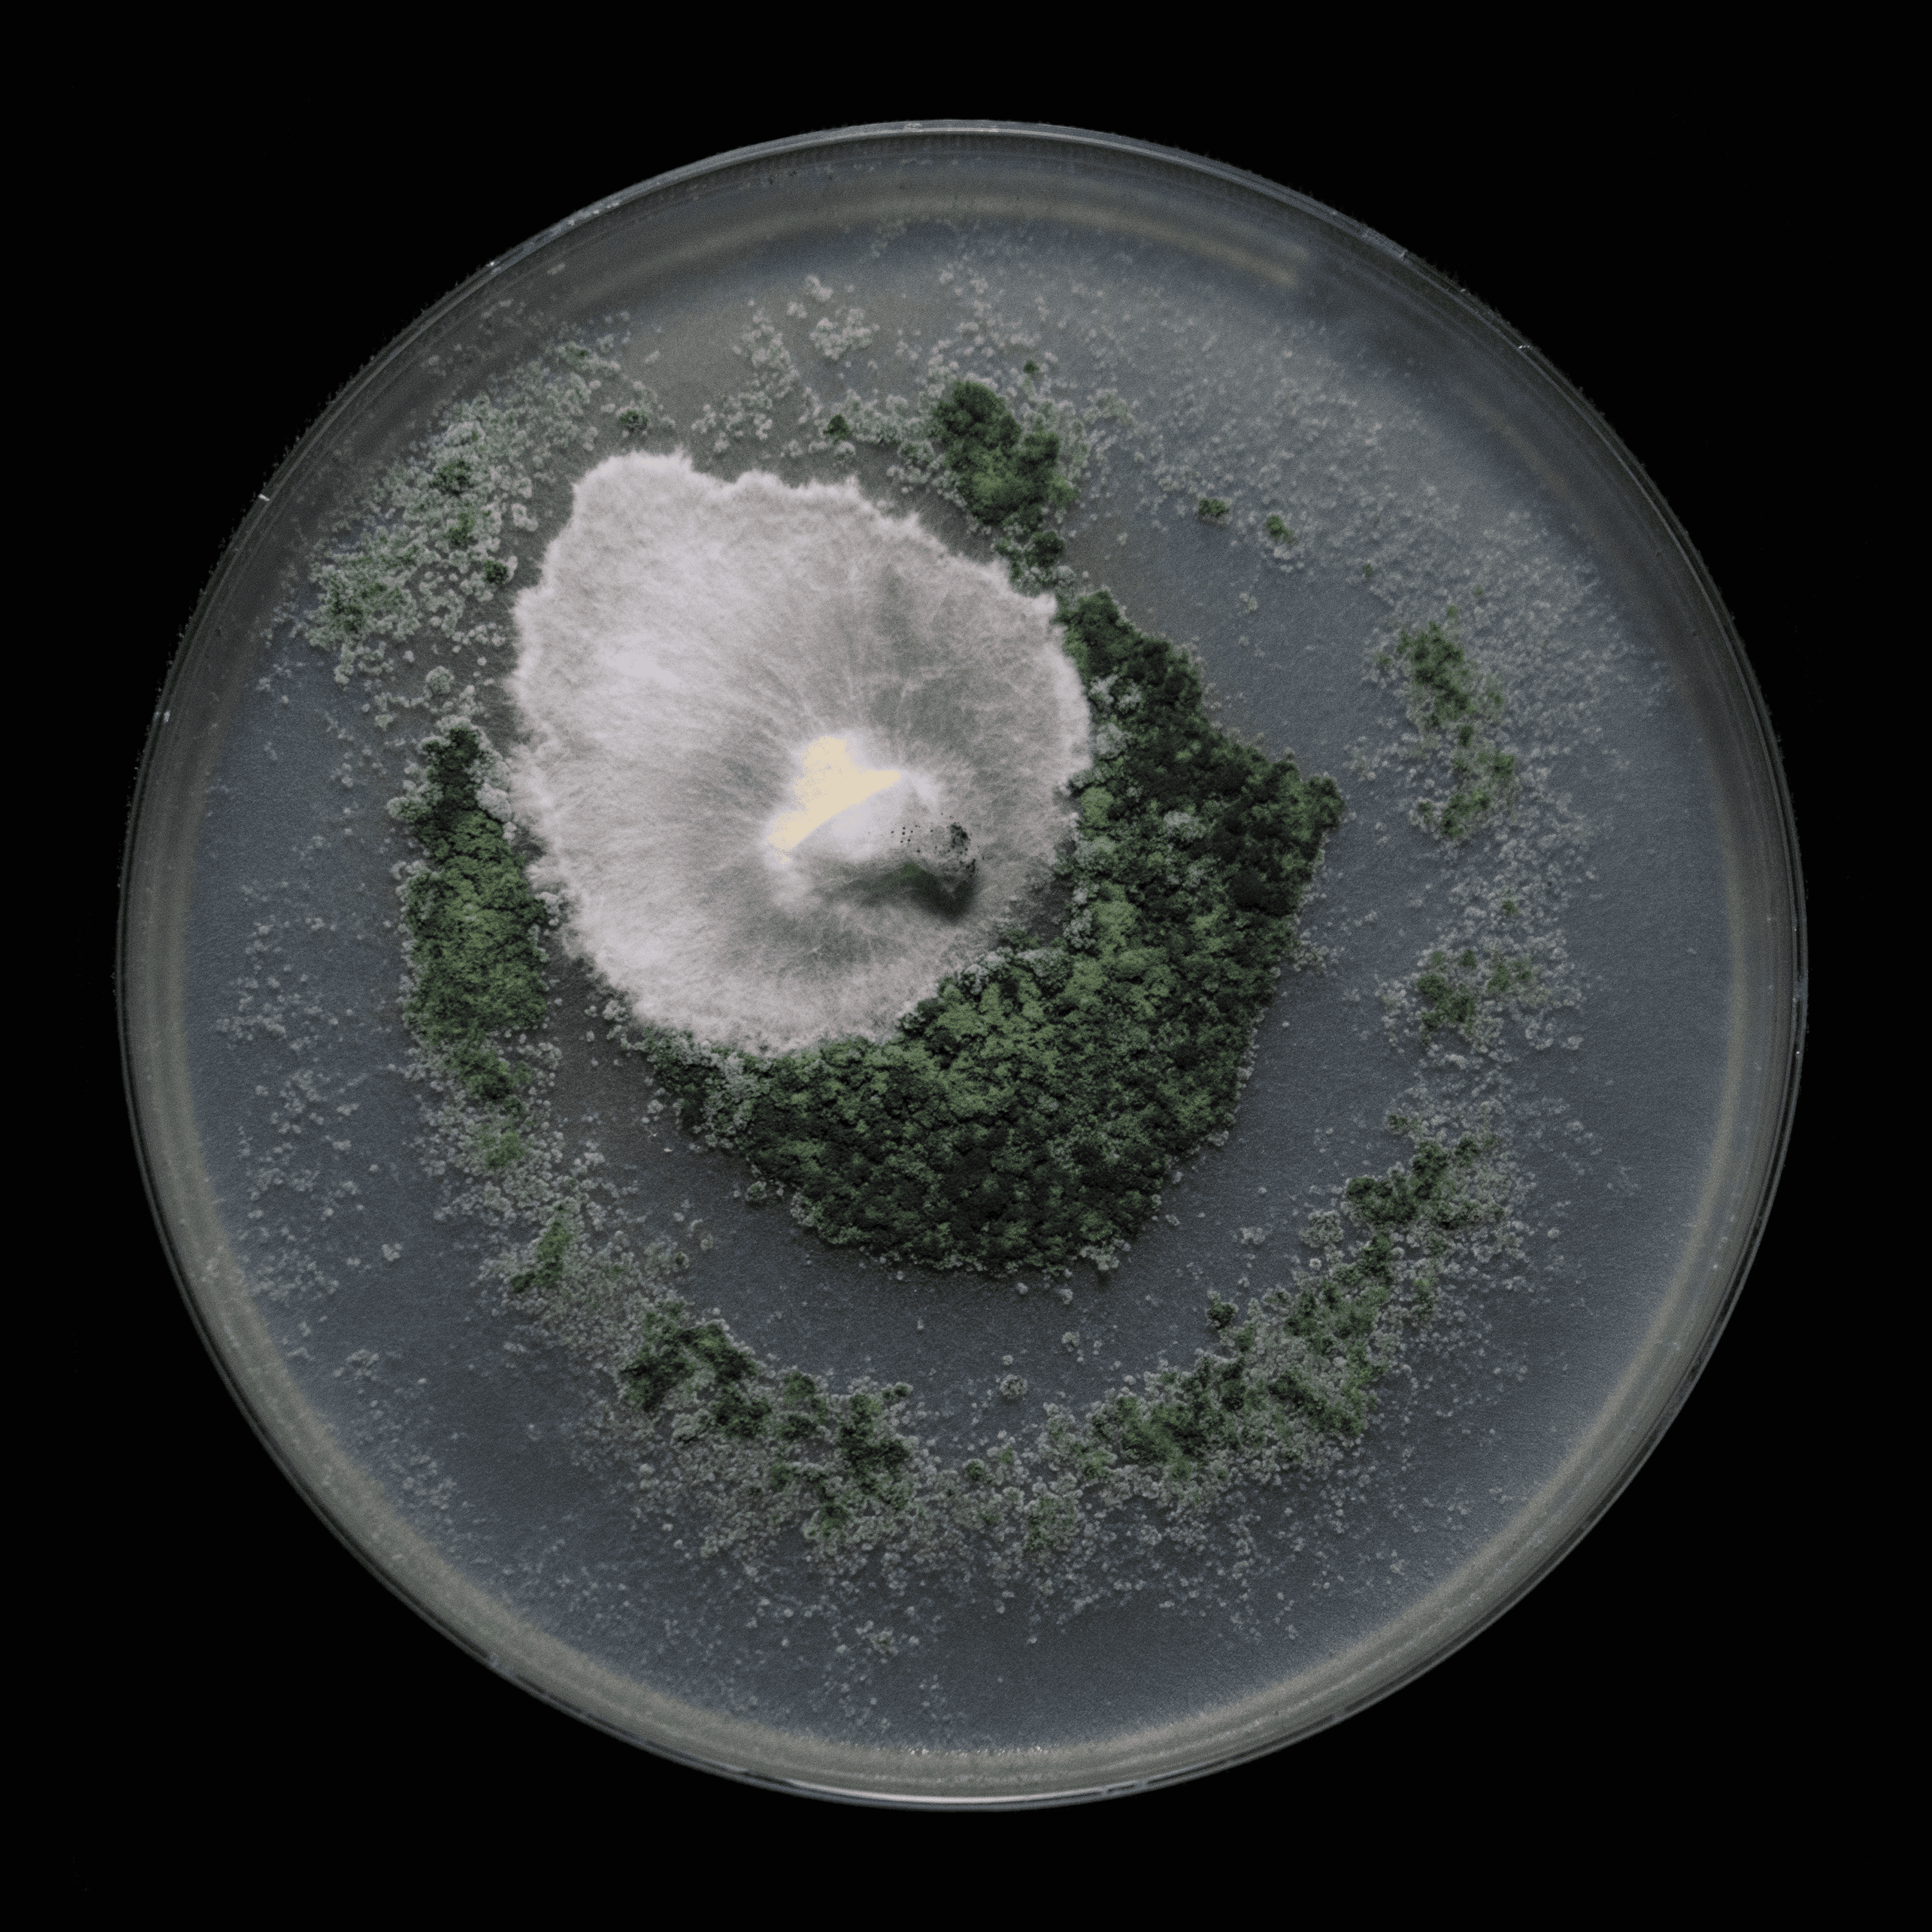
Obra de Horacio Flores: pieza 2 de la serie

Proyecto
Rizomática
Crecer desde las conexiones.
Un proyecto de gestión y producción artística que impulsa redes colaborativas en el ecosistema cultural del Nordeste Argentino. Inspirado en la lógica del rizoma, promueve conexiones horizontales, intercambio y expansión, fortaleciendo la proyección de artistas emergentes dentro del arte contemporáneo.

Nuestros Artistas
Cinco miradas que convergen en el territorio de la experimentación y el rescate de lo simbólico.
Horacio Flores
Territorios vivientes y biomateriales
Horacio Flores
Territorios vivientes y biomateriales
floreshoraciojA traves de materiales como fibras naturales y micelio de hongos, su trabajo explora el reino fungi como metafora de transformacion y co-creacion con la naturaleza. El crecimiento de estos organismos se convierte en un proceso compartido que habilita imaginar otras formas de existencia y relacion con lo vivo.
Su practica se despliega en diversos lenguajes como la escultura, instalacion, pintura, ceramica, fotografia y propuestas site-specific. Esta diversidad de medios potencia una investigacion sensible sobre la materia, el entorno y sus constantes mutaciones.


.png&w=3840&q=75)
.jpg&w=3840&q=75)
.jpg&w=3840&q=75)